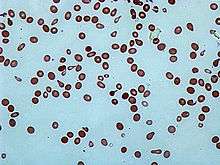

Poikilocytosis
| Poikilocytosis | |
|---|---|
![]() | |
| Acanthocytosis is one form of poikilocytosis | |
| Classification and external resources | |
| ICD-10 | R71 |
| ICD-9-CM | 790.09 |
| DiseasesDB | 10207 |
Poikilocytosis refers to the presence of poikilocytes in the blood. Poikilocytes are abnormally shaped red blood cells[1] as seen on a blood film in humans and many wild and domestic species of animals, though they are common in some clinically normal small ruminants, particularly goats.
Normal red blood cells are round, flattened disks that are thinner in the middle than at the edges. A poikilocyte is an abnormally shaped cell.[2] Generally, poikilocytosis can refer to an increase in abnormal red blood cells of any shape where they make up 10% or more of the total population.
Types
Membrane abnormalities
- Acanthocytes or Spur/Spike cells
- Codocytes or Target cells
- Echinocytes and Burr cells
- Elliptocytes and Ovalocytes
- Spherocytes
- Stomatocytes or Mouth cells
- Drepanocytes or Sickle Cells
- Degmacytes or "bite cells"
Trauma
- Dacrocytes or Teardrop Cells
- Keratocytes
- Microspherocytes and Pyropoikilocytes
- Schistocytes
- Semilunar bodies
Treatment
In all cases, the treatment of poikilocytosis depends on its cause. For example, poikilocytosis can be caused by a vitamin deficiency (e.g. vitamin B12 or folic acid), in which case the treatment is to replenish the deficient vitamin. It can be caused by a digestive disease, such as celiac disease, in which case the solution may lie in treating the underlying celiac disease so that nutrients can be properly absorbed.
Etymology
The term derives from poikilos (ποικίλος), which means "varied" in Ancient Greek.[3][4]
See also
References
- ↑ "poikilocyte" at Dorland's Medical Dictionary
- ↑ Barbara J. Bain (2006). Blood cells: a practical guide. Wiley-Blackwell. pp. 71–. ISBN 978-1-4051-4265-6. Retrieved 10 November 2010.
- ↑ (Greek) Triantafyllidis Online Lexicon, ποικιλόθερμος, Retrieved on 2007-01-12
- ↑ "poikilo-". Wiktionary. Retrieved 14 October 2011.
